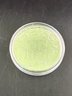
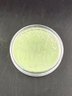

×
☰ - Find a Seller
- 1920 Enterprises LLC
- 1st Place Online Auctions LLC
- 2 Sisters Trading Post
- 21st Century Antiques
- 2nd Time Around
- 3 Little Witches
- 3JRETAIL
- 417 Estate Liquidations
- 44 North Estate Sales LLC
- 5150 Auctions
- 5280 Estate Solutions
- A Metafair Sale
- A White Goose Estate Sales
- A&E Estate Sales
- A.C. Lion Inc.
- Aardvark Estate Services and Appraisals, LLC
- ABC Estate Services & Hoarder Specialists
- Acorn Estate Sales
- Across The Block Auctions
- Alighieri's
- All About REAL Furniture
- All American Tag Sales
- All Pro Estate Sales
- All Seasons All Reasons Estates
- All-Star Estate and Tag Sales
- American Online Auction Company
- Americana Estates & Liquidations
- Anchors Away Estate Sales
- Ancient and Modern
- Anne and Anna Estate Sale Services
- Ans Antiques
- Antiques at Northport
- Antivico LLC
- Apocardlypse Now Sports Cards and Collectibles
- Arapahoe Acres Antiques and Collectibles
- Archival Antiques
- Artifacts2go Auction House
- Artlantic Trades XXIV
- Ashcroft And Moore LLC
- Associated Estate & Appraisal Co., Inc.
- Auction Block (We Ship)
- Auction House Galleries, USA
- AuctionFever
- AuctionNinja Demo
- Auctions By Smith's
- Auctions Unlimited of Colorado, LLC
- Audris Attic
- Auntie Babs Estate Sales & More...
- Avant Garde Estate Sales
- Aversa Estate Sales
- Awesome Auctions
- B Luxe Designs
- Baneberry LLC
- Bargain Baloo
- Bargain Hunters Paradise Auction
- Barros Auctions
- Barton Co.
- Beacon Auctions & Estate Services LLC
- Beehive Bargains LLC
- Benchmark Office Systems Inc
- Bend Village Estate Services
- Benjamin Chaput
- Berkshire Legacy, LLC.
- Berlin Auction Group
- Best Treasures LLC
- Bethesda Auction
- BHOME LV INC.
- BID FOR DECOR
- Bid to Win NH Auction
- Billy Reyes
- Bird's Nest Auctions
- Black Rock Galleries
- Blackstone Valley Auctions & Estates LLC
- Blackthorn House Auctions
- Bling and Brush
- Blue Moon Estate Sales
- Blue Moon Estate Sales of Central Jersey
- Blue Moon Estate Sales Westchester South
- Blue Nest Home
- Blue Spruce Estate Sales
- Bluebird Estate Sales, LLC
- Boulder Auctions
- Bountiful Auctions by Stockbridge and Berry
- BPM Services
- Bretton ART USA LLC
- Bridge Hill Estate Sales LLC
- Brooks and Miller
- Brooks Bargains Inc.
- Brown Tag Estate Sales
- Brownstone Liquidators
- Buckley Estate Sales
- Burlington Antiques
- But Not Forgotten Antiques
- By Your Side Estate Sales
- C&C Antiques
- C2C Home Edit
- Cabin Fever Solutions
- Calix Books
- Can-DC Island Auctions
- Candlewood Trading Company
- Cape Ann Auction
- CARDS, COINS, AND COLLECTIBLES LLC
- Carnival Antiques
- Carolina Antique
- Casco Bay Auctions
- Cassie Cares Estate Sales and Consignment
- Charles Street Auctions
- Chatsworth IV Antiques
- Chebacco Hill Carpentry and Consignments
- Chief Estates Inc.
- Christine May LLC
- Clearing House Estate Sales
- Clearing House Estate Sales - NC
- CLOAK AND MIRROR
- Closeouts and Liquidations
- Coastal Coins LLC
- Cold Summit Collectibles LLC
- Collection W
- collectors corner
- Colorado Consignment and Resale Connections
- Colorful Colorado Estate Sales
- Columbine Estate Sales LLC
- Come Find Your Treasure
- Complete Cleanouts
- Consignment Corner INC.
- Countrysidetrading (WE SHIP)
- Craigs Closet
- CT Auction Gallery
- CT Auction Group
- CTIWY
- Culper's
- Cummings and Associates
- Cup And Cloth LLC
- D.Cleveland Auctions
- Darien Scouts
- Decade Dance LLC
- Denver Metro Estate Services
- Derry Auction Center
- Devin Moisan Auctioneers, Inc.
- DGW Collectibles & Estates
- Diamond Silhouette Collection
- Diamond Tag Sales
- Dirty Work Vintage
- Doll Auction
- Donnelly & Donnelly Appraisals & Estate Sale Svcs
- Dons Estate Sales
- Drumm's Antiques
- Duck On A Pig
- Dude's Auction House LLC
- Dumpster Rescuers Ltd.
- East India Connection Inc
- East Star LLC
- East-Wing Estate Sales & Auction Co.
- Eastern Art Services
- Easy Estate Auctions
- EB Antiques LLC
- Edward B. Beattie Auctioneers
- Electric City Auctions
- Eliyaahs Estate Sales Find LLC
- Elles Auction House
- Emet Estates
- Epic Estate Sales and Cleanouts INC.
- Equitable Auctions LLC
- Erbs Vintage LLC
- Essentia Endeavors, Ltd
- Estate Acquisitions LLC
- Estate Alchemy
- Estate Antiques
- Estate Inventory Auctions
- Estate Luxuries and Treasures LLC
- Estate Rarities Worldwide
- Estate Sales By Jesod LLC
- Estate Solutions of the Catawba Valley
- Evergreen Tag and Estate Sales
- Every Little Thing Estate Sales
- Excess Estate Sales
- Executive Estate Auctions
- Eyegallery.com, Inc.
- Fairfield County Coins, Stamps and Collectibles
- Fairfield County Consignments LLC
- Fairlight Estate Sales
- Ferris Fluffs, LLC
- Filling Gold and Silver Exchange llc
- Final Chapter Auctions.inc DBA Saturn Trading
- Finally Found It, LLC
- Fine Oriental Rug Gallery
- Finely Find It Vintage!
- Flatwater Estate Sales, LLC
- Flynn's Estate Sales
- Forest Hills Estate Auctions
- Foss Appraisal Service
- Freeman Coins & Collectibles
- Front Porch Estate Sales
- Fruitcocktail Collectables Appraisal Services
- Full Circle Estate and Tag Sale Services LLC
- Full House Auctions
- Full of Surprizes Estate and Tag Sales Auctions
- Fun and Funky Vintage LLC
- G W Bell Antiques & Auctions
- G's Treasures
- Gaynor's Fine Consignments
- Girlfriends Estate Sales
- Glass Slipper Enterprises
- Global Village Museum
- GMMN Estate liquidators llc dba CollectorAddict
- Going Going Gone LLC
- Gold Coast Auction
- Gold Diggers Pawn (WE SHIP)
- Golden Gavel LLC
- Goldens Estate Sales and Cleanouts, LLC
- GoldenTree Team LLC
- Good Samaritan Luxury LLC
- Gotta Have It
- Great Estate Sales and Finds
- Great Northern Liquidation
- Green Truck Antiques
- Greenhouse Antiques
- Grey Dog Liquidation
- Gulf Coast Estate Auctions
- Gurley Auction Company
- H G Webber Antiques
- Habitat for Humanity of Dutchess County, Inc.
- Halcyon Estate Services
- Hall and Sons Antique and Collectibles
- Hall Of Vintage (WE SHIP)
- Hamilton Group LLC
- Hampton Estate Sales by Denise
- Hamptons Auction House
- Harmony Road Estate Sales
- Hassle Free Estate Sales, LLC
- Heather Tobin Auctions
- Hecks Things and Things
- Heinz Consulting LLC
- Heirlooms Auction Gallery
- Heirlooms, LLC
- Helen's Bargains And Treasures LLC
- Heritage Estate Sales and Liquidation, LLC
- Heritage Gallery Auctions
- Heritage Home Furnishings LLC
- Hewitt Estates and Antiques
- Hidden Treasures - Collectibles
- Hidden Treasures Flea Market
- High Draw Partners Inc.
- hollywood and history llc.
- Home Again Consignments
- Home Inspirations llc
- Home Solutions by Trinkets and Treasures
- Homestead Estate Services
- House of Jewels NYC
- Howell Artist
- HUB HOME
- Hudson Estate Sales
- Hunt and Gather Vintage Market LLC
- Hunter Trading Card Company
- Hurley And Sons Estate Liquidations
- IDEAL AUCTIONS LLC
- Invictus Auctions
- Invintage Colour
- Isabel and Celine
- It's Simply Done
- Ivory Tower LLC
- J & A Finds
- J and T Treasures LLC
- J n C Home Services
- JD FINDS LLC
- Jem Estate Sales
- JLW StudyRoom
- Junk and Disorderly Antiques
- Just In Antiques, LLC
- K & J Estate Sales
- Kaminski Auctions
- Katie's Consignment Sales and Auctions
- Keene Auctions
- Kennebunk Auction Gallery, LLC
- Kevs Finds LLC
- Kodi Korner
- Laceys Place
- LDS Liquidations
- Leave It To Lisa
- Legacy Estate and Liquidation
- Legacy In Bloom Estate Sales
- Legare Auctions
- LeMay & Co. Antiques & Estates
- Let It Go Tag Sales
- Lighter Spaces Clutter and Estate Solutions
- Lighthouse Antiques & Re Sale
- Lighthouse Estate Sales
- Little River Antiques & Estate Sales, LLC
- LJ Estate Sale
- Loluty Oddities
- Long Island Estate Liquidators
- Long Island Treasure
- lots_o_stuff4u
- Loveland Pickers Vintage Vault
- Luanne Meader Art & Antiques
- Lucky Dog Auctions
- Lucky Find
- Lucky Rabbit Estate Sales, Inc
- Luxe Treasures and Boutique Inc.
- LUXESWAP
- Luxury For All
- M B Eldorado
- Madison Jewels
- Magpies - The Nest Antiques
- Main Street Auction and Estate Liquidators
- Mallet Media
- Manatee River Auctions
- MarbleAlley
- Martins Estate Services
- Mastrangelo Auctions
- Mcinnis Auctioneers & Estate Sales, LLC
- MDD Auctions llc
- Meadowlark Estate Services
- Meehan Antiques
- Melo and Bailey Auctions
- Mercantile On Main
- Metro Auctions
- Michael Rosenstark
- Mid-Hudson Galleries Ltd
- Milestone Estate Services, LLC
- Milestone Road Antiques: Antique & Vintage Jewelry
- Mind Over Mountains Movement, Inc.
- Miss Spiffy Estate Sales, LLC
- Mobile Art Services
- Modern Realty Resources llc
- Modern Vintage Auctions
- MoJoe Auctions
- Monadnock Moon Vintage
- Monster Estate Sales Inc.
- Mountain View Estate Sales
- Mr Auction LLC
- MT2
- Muleshoe
- MV Auction Center
- My Kitsch Kitchen
- Never Ending Thrifts LLC
- New England Coin Exchange
- New England Estate Sales
- New England Estate Services NH, LLC
- New2ubut2ndhand4sure
- Nicole Sherwood Decor Inc
- NoCo Estate Sales LLC
- North Country Peddlers
- NorthEast Finds
- Northshore Christian Church
- Northwest Estate Sales
- Not So Plain Jayne's Junk
- Not Your Average Auction, LLC
- Oceanside Estate Sales
- odd aly-kat emporium llc
- Old Wagon Antique Mall
- Once and Again Auctions LLC
- Opus Creations
- Opus Estate Sales
- Orange County Clean Outs
- Orfantiques
- Oscar & Company
- Pacific Northwest Auctions
- PandP Vintage
- Park Hill Treasures
- Parkhill Auctions
- Past to Present, LLC
- Paul's Boutique
- Pete's Antiques
- Pickers Paradise Me
- Pickwick Papers Books & Antiques
- Pine Tree Transition Services
- Pink Lagoon
- PixelThrift
- PNW Treasure Trove
- POMPEO AUCTIONS & ESTATES
- Posh Pickins and Perfect Pieces
- Premier Auctioneer at SILVER AND GOLD EMPORIUM
- Prestige Auction House LLC
- Pretty City Home Staging INC
- Primetime Auctions LLC
- Printz and Co LLC
- Privet Estate Sales
- Provenance Auctions
- Puggy's Auctions
- Pullman & Comley, LLC
- Pynette Sales & Auction
- Queen Bee Thrifts and Resales
- Queen City Sports Cards
- Rain City Estate Sales, LLC
- Rainbow Relics
- Randall Hill Auctioneers
- RC Antiques Collectables Estate Liquidations
- Re Antiques and Interiors
- Real Vintage of New England
- Recollect to Collect LLC
- Red Hill Resale LLC
- Rediscovered Treasures
- ReHome Estate Sales
- ReluxeHamptons
- Remember Yesteryears Antique & Vintage Center
- Replay Sales and Service LLC
- Resold LLC
- Resort Estate Liquidation
- Retro Roadshow
- Revivals
- Ridgefield Thrift Shop
- Ridgeways Estate Sales
- Rightsize and Renew LLC
- Roadside Relics Auctions
- Robert Monaco's Voodoo Antiques and Collectibles
- Rocky mountain treasures ltd
- RockyMountainHigh LLC
- Rolling Hills Estate Sales
- Rowland Thomas Co. LLC
- Roxbury Auctions
- Royal Bellew Auctions LLC
- RSS Auctions, LLC
- Rusty Treasures
- ryders auction
- S&L Coins and Collectibles LLC
- S.E.L.I. Select Estate Liquidation Items
- Sam's Discount World
- Sarah's Estate Services
- Say-Chelles Auctions, LLC
- Sayville Antiques
- Scoops Auction
- Sean Mahoney Estate Sales LLC
- Seattle Magpies
- Seattle Organizing Works
- Second Chance Treasures
- Second House Vintage, LLC
- Sell My Stuff
- Shawe Valley Sports Cards (We Ship)
- Signature Estate Sales llc
- Silver and Gold Estate Sales
- Silver Creek Antique and Estate
- Simmons Auction House
- Simple Sale Auctions
- Simplify with Eileen Estate Sales
- Simply Home Consignments & Gifts
- Sisters Estate Sales, LLC
- Sisters In Charge Estate Sales
- SJD Auctions
- SmartBid Auctions LLC
- Smartsale3M
- Snowhill Auctions
- Sound Artifacts Vintage LLC
- South Street Auctions
- SpicyAuctions.com
- Star Coin and Currency, LLC
- Stark Brothers' Auctions
- Statewide Liquidators
- Step Back Studio
- Stephen P. Cyr Auction Company
- Sterling Harbor Estate Sales
- Storage Assets
- Stress Free Estate Services LLC
- Stuff Estate Services LLC
- Summer Valley Supplies Inc.
- Sun Auctions
- Sundown Modern Vintage and Estate Sales, LLC
- Sunflower Estate Sales
- Sunglo Antiques & Coins (We Ship!)
- SunGroup Real Estate
- Superdopedeals
- Sweet Hollow Antiques
- Tag Masters
- TAG Sales
- Tavvy and Rose LLC
- TCC
- The Card Arcade
- The Estate Kings
- The Gildedlillie LLC
- The Gold Standard
- The Hilltop Gallery
- The J Art
- THE JUNK AND DISORDERLY GIRLS
- The Modern Manor House
- The Nest Marketplace LLC
- The Otto Shop
- The Outlet LLC
- The Pickers Alley
- The Popular Pioneer
- The Prairie Attic
- The Source Antiques
- The Time Traveler's Emporium LLC
- The Toy and Collectibles Exchage
- The Unit CT
- The Vintage Finders
- The War Front LLC
- TheLeoAndHoneyShow LLC
- Things & Stuff Auctions
- Things Matter
- This that and the other thing
- Time Gallery
- Timeless Relics What-Knots
- Timeless Toy Box
- Timeless Treasures Estate Sales
- TJR Inc
- TLC'S Estate Sales
- To Do Ta Done, LLC
- To Infinity Sales (WE SHIP)
- Tradeport USA LLC
- Trading Post Estate Sales
- Trading Works Inc
- Tranzon Auction Properties
- Treasure & Thyme
- Treasure Chest Estate Sales
- Treasure Deck Auctions LLC
- Treasure Hunters Auctions
- Treasure Hunting Co.
- Treasure New And Old LLC
- Treasured Auctions
- Treasures of the Heart
- Turtle Treasure Auctions
- Tuxedo Park Junk Shop
- Twilight Estate Sales
- Twin State Auctions
- Two Chefs Gallery - Amelies llc
- Union Kettle Auctions LLC
- Unique Antiques
- Unity Sales
- URBN MRKT
- Vacationland Home
- Valley Farm Antiques
- Variety Auctions LLC
- Vinnie's Antiques and Uniques LLC
- Vintage Estate Company
- Vintage Haus LLC
- Vintage Home Center
- Vintage Time Travelers
- Vintage Venerers L.L.C.
- Vintage Vin Auctions
- Vintique Estate Sales
- VM Madden collections
- Waterbury Auction Gallery
- We Empowerment
- We Liquidate It
- We Move Your Mom
- What's in the box?
- White Mtns Estate Services
- White Rabbit Riches, Inc.
- Windsor Estates Auctions
- Winney Auction & Appraisal LLC
- WinsorAntiques
- Withington Auction, Inc.
- Woodbury Auction
- Woodruff Furniture
- Yesteryear Designs
- Your Mothers House Antiques
- Zach and Alix LTD
- Browse Items
- Architectural Salvage
- Clothing & Fashion Accessories
- Coins & Stamps
- Commercial & Industrial Equipment
- Electronics & Computers
- Exercise & Sporting Equipment
- Fine Art
- Furniture
- Garage & Tools
- Home Decor Auctions
- Housewares
- Jewelry & Watches
- Lawn & Garden
- Lighting
- Militaria
- Motor Vehicles
- Music & Musical Instruments
- Silver & Silver Plate
- Sports Memorabilia, Trading Cards & Ephemera
- Toys & Video Gaming
- View All Auctions
- Auctions
- Estate Sales
- About Us
- Sell on AuctionNinja
- Hire an Estate Sale Company
- Buying Guides & Tips
- Find a Seller
All Sellers
- 1920 Enterprises LLC
- 1st Place Online Auctions LLC
- 2 Sisters Trading Post
- 21st Century Antiques
- 2nd Time Around
- 3 Little Witches
- 3JRETAIL
- 417 Estate Liquidations
- 44 North Estate Sales LLC
- 5150 Auctions
- 5280 Estate Solutions
- A Metafair Sale
- A White Goose Estate Sales
- A&E Estate Sales
- A.C. Lion Inc.
- Aardvark Estate Services and Appraisals, LLC
- ABC Estate Services & Hoarder Specialists
- Acorn Estate Sales
- Across The Block Auctions
- Alighieri's
- All About REAL Furniture
- All American Tag Sales
- All Pro Estate Sales
- All Seasons All Reasons Estates
- All-Star Estate and Tag Sales
- American Online Auction Company
- Americana Estates & Liquidations
- Anchors Away Estate Sales
- Ancient and Modern
- Anne and Anna Estate Sale Services
- Ans Antiques
- Antiques at Northport
- Antivico LLC
- Apocardlypse Now Sports Cards and Collectibles
- Arapahoe Acres Antiques and Collectibles
- Archival Antiques
- Artifacts2go Auction House
- Artlantic Trades XXIV
- Ashcroft And Moore LLC
- Associated Estate & Appraisal Co., Inc.
- Auction Block (We Ship)
- Auction House Galleries, USA
- AuctionFever
- AuctionNinja Demo
- Auctions By Smith's
- Auctions Unlimited of Colorado, LLC
- Audris Attic
- Auntie Babs Estate Sales & More...
- Avant Garde Estate Sales
- Aversa Estate Sales
- Awesome Auctions
- B Luxe Designs
- Baneberry LLC
- Bargain Baloo
- Bargain Hunters Paradise Auction
- Barros Auctions
- Barton Co.
- Beacon Auctions & Estate Services LLC
- Beehive Bargains LLC
- Benchmark Office Systems Inc
- Bend Village Estate Services
- Benjamin Chaput
- Berkshire Legacy, LLC.
- Berlin Auction Group
- Best Treasures LLC
- Bethesda Auction
- BHOME LV INC.
- BID FOR DECOR
- Bid to Win NH Auction
- Billy Reyes
- Bird's Nest Auctions
- Black Rock Galleries
- Blackstone Valley Auctions & Estates LLC
- Blackthorn House Auctions
- Bling and Brush
- Blue Moon Estate Sales
- Blue Moon Estate Sales of Central Jersey
- Blue Moon Estate Sales Westchester South
- Blue Nest Home
- Blue Spruce Estate Sales
- Bluebird Estate Sales, LLC
- Boulder Auctions
- Bountiful Auctions by Stockbridge and Berry
- BPM Services
- Bretton ART USA LLC
- Bridge Hill Estate Sales LLC
- Brooks and Miller
- Brooks Bargains Inc.
- Brown Tag Estate Sales
- Brownstone Liquidators
- Buckley Estate Sales
- Burlington Antiques
- But Not Forgotten Antiques
- By Your Side Estate Sales
- C&C Antiques
- C2C Home Edit
- Cabin Fever Solutions
- Calix Books
- Can-DC Island Auctions
- Candlewood Trading Company
- Cape Ann Auction
- CARDS, COINS, AND COLLECTIBLES LLC
- Carnival Antiques
- Carolina Antique
- Casco Bay Auctions
- Cassie Cares Estate Sales and Consignment
- Charles Street Auctions
- Chatsworth IV Antiques
- Chebacco Hill Carpentry and Consignments
- Chief Estates Inc.
- Christine May LLC
- Clearing House Estate Sales
- Clearing House Estate Sales - NC
- CLOAK AND MIRROR
- Closeouts and Liquidations
- Coastal Coins LLC
- Cold Summit Collectibles LLC
- Collection W
- collectors corner
- Colorado Consignment and Resale Connections
- Colorful Colorado Estate Sales
- Columbine Estate Sales LLC
- Come Find Your Treasure
- Complete Cleanouts
- Consignment Corner INC.
- Countrysidetrading (WE SHIP)
- Craigs Closet
- CT Auction Gallery
- CT Auction Group
- CTIWY
- Culper's
- Cummings and Associates
- Cup And Cloth LLC
- D.Cleveland Auctions
- Darien Scouts
- Decade Dance LLC
- Denver Metro Estate Services
- Derry Auction Center
- Devin Moisan Auctioneers, Inc.
- DGW Collectibles & Estates
- Diamond Silhouette Collection
- Diamond Tag Sales
- Dirty Work Vintage
- Doll Auction
- Donnelly & Donnelly Appraisals & Estate Sale Svcs
- Dons Estate Sales
- Drumm's Antiques
- Duck On A Pig
- Dude's Auction House LLC
- Dumpster Rescuers Ltd.
- East India Connection Inc
- East Star LLC
- East-Wing Estate Sales & Auction Co.
- Eastern Art Services
- Easy Estate Auctions
- EB Antiques LLC
- Edward B. Beattie Auctioneers
- Electric City Auctions
- Eliyaahs Estate Sales Find LLC
- Elles Auction House
- Emet Estates
- Epic Estate Sales and Cleanouts INC.
- Equitable Auctions LLC
- Erbs Vintage LLC
- Essentia Endeavors, Ltd
- Estate Acquisitions LLC
- Estate Alchemy
- Estate Antiques
- Estate Inventory Auctions
- Estate Luxuries and Treasures LLC
- Estate Rarities Worldwide
- Estate Sales By Jesod LLC
- Estate Solutions of the Catawba Valley
- Evergreen Tag and Estate Sales
- Every Little Thing Estate Sales
- Excess Estate Sales
- Executive Estate Auctions
- Eyegallery.com, Inc.
- Fairfield County Coins, Stamps and Collectibles
- Fairfield County Consignments LLC
- Fairlight Estate Sales
- Ferris Fluffs, LLC
- Filling Gold and Silver Exchange llc
- Final Chapter Auctions.inc DBA Saturn Trading
- Finally Found It, LLC
- Fine Oriental Rug Gallery
- Finely Find It Vintage!
- Flatwater Estate Sales, LLC
- Flynn's Estate Sales
- Forest Hills Estate Auctions
- Foss Appraisal Service
- Freeman Coins & Collectibles
- Front Porch Estate Sales
- Fruitcocktail Collectables Appraisal Services
- Full Circle Estate and Tag Sale Services LLC
- Full House Auctions
- Full of Surprizes Estate and Tag Sales Auctions
- Fun and Funky Vintage LLC
- G W Bell Antiques & Auctions
- G's Treasures
- Gaynor's Fine Consignments
- Girlfriends Estate Sales
- Glass Slipper Enterprises
- Global Village Museum
- GMMN Estate liquidators llc dba CollectorAddict
- Going Going Gone LLC
- Gold Coast Auction
- Gold Diggers Pawn (WE SHIP)
- Golden Gavel LLC
- Goldens Estate Sales and Cleanouts, LLC
- GoldenTree Team LLC
- Good Samaritan Luxury LLC
- Gotta Have It
- Great Estate Sales and Finds
- Great Northern Liquidation
- Green Truck Antiques
- Greenhouse Antiques
- Grey Dog Liquidation
- Gulf Coast Estate Auctions
- Gurley Auction Company
- H G Webber Antiques
- Habitat for Humanity of Dutchess County, Inc.
- Halcyon Estate Services
- Hall and Sons Antique and Collectibles
- Hall Of Vintage (WE SHIP)
- Hamilton Group LLC
- Hampton Estate Sales by Denise
- Hamptons Auction House
- Harmony Road Estate Sales
- Hassle Free Estate Sales, LLC
- Heather Tobin Auctions
- Hecks Things and Things
- Heinz Consulting LLC
- Heirlooms Auction Gallery
- Heirlooms, LLC
- Helen's Bargains And Treasures LLC
- Heritage Estate Sales and Liquidation, LLC
- Heritage Gallery Auctions
- Heritage Home Furnishings LLC
- Hewitt Estates and Antiques
- Hidden Treasures - Collectibles
- Hidden Treasures Flea Market
- High Draw Partners Inc.
- hollywood and history llc.
- Home Again Consignments
- Home Inspirations llc
- Home Solutions by Trinkets and Treasures
- Homestead Estate Services
- House of Jewels NYC
- Howell Artist
- HUB HOME
- Hudson Estate Sales
- Hunt and Gather Vintage Market LLC
- Hunter Trading Card Company
- Hurley And Sons Estate Liquidations
- IDEAL AUCTIONS LLC
- Invictus Auctions
- Invintage Colour
- Isabel and Celine
- It's Simply Done
- Ivory Tower LLC
- J & A Finds
- J and T Treasures LLC
- J n C Home Services
- JD FINDS LLC
- Jem Estate Sales
- JLW StudyRoom
- Junk and Disorderly Antiques
- Just In Antiques, LLC
- K & J Estate Sales
- Kaminski Auctions
- Katie's Consignment Sales and Auctions
- Keene Auctions
- Kennebunk Auction Gallery, LLC
- Kevs Finds LLC
- Kodi Korner
- Laceys Place
- LDS Liquidations
- Leave It To Lisa
- Legacy Estate and Liquidation
- Legacy In Bloom Estate Sales
- Legare Auctions
- LeMay & Co. Antiques & Estates
- Let It Go Tag Sales
- Lighter Spaces Clutter and Estate Solutions
- Lighthouse Antiques & Re Sale
- Lighthouse Estate Sales
- Little River Antiques & Estate Sales, LLC
- LJ Estate Sale
- Loluty Oddities
- Long Island Estate Liquidators
- Long Island Treasure
- lots_o_stuff4u
- Loveland Pickers Vintage Vault
- Luanne Meader Art & Antiques
- Lucky Dog Auctions
- Lucky Find
- Lucky Rabbit Estate Sales, Inc
- Luxe Treasures and Boutique Inc.
- LUXESWAP
- Luxury For All
- M B Eldorado
- Madison Jewels
- Magpies - The Nest Antiques
- Main Street Auction and Estate Liquidators
- Mallet Media
- Manatee River Auctions
- MarbleAlley
- Martins Estate Services
- Mastrangelo Auctions
- Mcinnis Auctioneers & Estate Sales, LLC
- MDD Auctions llc
- Meadowlark Estate Services
- Meehan Antiques
- Melo and Bailey Auctions
- Mercantile On Main
- Metro Auctions
- Michael Rosenstark
- Mid-Hudson Galleries Ltd
- Milestone Estate Services, LLC
- Milestone Road Antiques: Antique & Vintage Jewelry
- Mind Over Mountains Movement, Inc.
- Miss Spiffy Estate Sales, LLC
- Mobile Art Services
- Modern Realty Resources llc
- Modern Vintage Auctions
- MoJoe Auctions
- Monadnock Moon Vintage
- Monster Estate Sales Inc.
- Mountain View Estate Sales
- Mr Auction LLC
- MT2
- Muleshoe
- MV Auction Center
- My Kitsch Kitchen
- Never Ending Thrifts LLC
- New England Coin Exchange
- New England Estate Sales
- New England Estate Services NH, LLC
- New2ubut2ndhand4sure
- Nicole Sherwood Decor Inc
- NoCo Estate Sales LLC
- North Country Peddlers
- NorthEast Finds
- Northshore Christian Church
- Northwest Estate Sales
- Not So Plain Jayne's Junk
- Not Your Average Auction, LLC
- Oceanside Estate Sales
- odd aly-kat emporium llc
- Old Wagon Antique Mall
- Once and Again Auctions LLC
- Opus Creations
- Opus Estate Sales
- Orange County Clean Outs
- Orfantiques
- Oscar & Company
- Pacific Northwest Auctions
- PandP Vintage
- Park Hill Treasures
- Parkhill Auctions
- Past to Present, LLC
- Paul's Boutique
- Pete's Antiques
- Pickers Paradise Me
- Pickwick Papers Books & Antiques
- Pine Tree Transition Services
- Pink Lagoon
- PixelThrift
- PNW Treasure Trove
- POMPEO AUCTIONS & ESTATES
- Posh Pickins and Perfect Pieces
- Premier Auctioneer at SILVER AND GOLD EMPORIUM
- Prestige Auction House LLC
- Pretty City Home Staging INC
- Primetime Auctions LLC
- Printz and Co LLC
- Privet Estate Sales
- Provenance Auctions
- Puggy's Auctions
- Pullman & Comley, LLC
- Pynette Sales & Auction
- Queen Bee Thrifts and Resales
- Queen City Sports Cards
- Rain City Estate Sales, LLC
- Rainbow Relics
- Randall Hill Auctioneers
- RC Antiques Collectables Estate Liquidations
- Re Antiques and Interiors
- Real Vintage of New England
- Recollect to Collect LLC
- Red Hill Resale LLC
- Rediscovered Treasures
- ReHome Estate Sales
- ReluxeHamptons
- Remember Yesteryears Antique & Vintage Center
- Replay Sales and Service LLC
- Resold LLC
- Resort Estate Liquidation
- Retro Roadshow
- Revivals
- Ridgefield Thrift Shop
- Ridgeways Estate Sales
- Rightsize and Renew LLC
- Roadside Relics Auctions
- Robert Monaco's Voodoo Antiques and Collectibles
- Rocky mountain treasures ltd
- RockyMountainHigh LLC
- Rolling Hills Estate Sales
- Rowland Thomas Co. LLC
- Roxbury Auctions
- Royal Bellew Auctions LLC
- RSS Auctions, LLC
- Rusty Treasures
- ryders auction
- S&L Coins and Collectibles LLC
- S.E.L.I. Select Estate Liquidation Items
- Sam's Discount World
- Sarah's Estate Services
- Say-Chelles Auctions, LLC
- Sayville Antiques
- Scoops Auction
- Sean Mahoney Estate Sales LLC
- Seattle Magpies
- Seattle Organizing Works
- Second Chance Treasures
- Second House Vintage, LLC
- Sell My Stuff
- Shawe Valley Sports Cards (We Ship)
- Signature Estate Sales llc
- Silver and Gold Estate Sales
- Silver Creek Antique and Estate
- Simmons Auction House
- Simple Sale Auctions
- Simplify with Eileen Estate Sales
- Simply Home Consignments & Gifts
- Sisters Estate Sales, LLC
- Sisters In Charge Estate Sales
- SJD Auctions
- SmartBid Auctions LLC
- Smartsale3M
- Snowhill Auctions
- Sound Artifacts Vintage LLC
- South Street Auctions
- SpicyAuctions.com
- Star Coin and Currency, LLC
- Stark Brothers' Auctions
- Statewide Liquidators
- Step Back Studio
- Stephen P. Cyr Auction Company
- Sterling Harbor Estate Sales
- Storage Assets
- Stress Free Estate Services LLC
- Stuff Estate Services LLC
- Summer Valley Supplies Inc.
- Sun Auctions
- Sundown Modern Vintage and Estate Sales, LLC
- Sunflower Estate Sales
- Sunglo Antiques & Coins (We Ship!)
- SunGroup Real Estate
- Superdopedeals
- Sweet Hollow Antiques
- Tag Masters
- TAG Sales
- Tavvy and Rose LLC
- TCC
- The Card Arcade
- The Estate Kings
- The Gildedlillie LLC
- The Gold Standard
- The Hilltop Gallery
- The J Art
- THE JUNK AND DISORDERLY GIRLS
- The Modern Manor House
- The Nest Marketplace LLC
- The Otto Shop
- The Outlet LLC
- The Pickers Alley
- The Popular Pioneer
- The Prairie Attic
- The Source Antiques
- The Time Traveler's Emporium LLC
- The Toy and Collectibles Exchage
- The Unit CT
- The Vintage Finders
- The War Front LLC
- TheLeoAndHoneyShow LLC
- Things & Stuff Auctions
- Things Matter
- This that and the other thing
- Time Gallery
- Timeless Relics What-Knots
- Timeless Toy Box
- Timeless Treasures Estate Sales
- TJR Inc
- TLC'S Estate Sales
- To Do Ta Done, LLC
- To Infinity Sales (WE SHIP)
- Tradeport USA LLC
- Trading Post Estate Sales
- Trading Works Inc
- Tranzon Auction Properties
- Treasure & Thyme
- Treasure Chest Estate Sales
- Treasure Deck Auctions LLC
- Treasure Hunters Auctions
- Treasure Hunting Co.
- Treasure New And Old LLC
- Treasured Auctions
- Treasures of the Heart
- Turtle Treasure Auctions
- Tuxedo Park Junk Shop
- Twilight Estate Sales
- Twin State Auctions
- Two Chefs Gallery - Amelies llc
- Union Kettle Auctions LLC
- Unique Antiques
- Unity Sales
- URBN MRKT
- Vacationland Home
- Valley Farm Antiques
- Variety Auctions LLC
- Vinnie's Antiques and Uniques LLC
- Vintage Estate Company
- Vintage Haus LLC
- Vintage Home Center
- Vintage Time Travelers
- Vintage Venerers L.L.C.
- Vintage Vin Auctions
- Vintique Estate Sales
- VM Madden collections
- Waterbury Auction Gallery
- We Empowerment
- We Liquidate It
- We Move Your Mom
- What's in the box?
- White Mtns Estate Services
- White Rabbit Riches, Inc.
- Windsor Estates Auctions
- Winney Auction & Appraisal LLC
- WinsorAntiques
- Withington Auction, Inc.
- Woodbury Auction
- Woodruff Furniture
- Yesteryear Designs
- Your Mothers House Antiques
- Zach and Alix LTD
Featured Sellers - Browse Items
- Architectural Salvage
- Clothing & Fashion Accessories
- Coins & Stamps
- Commercial & Industrial Equipment
- Electronics & Computers
- Exercise & Sporting Equipment
- Fine Art
- Furniture
- Garage & Tools
- Home Decor Auctions
- Housewares
- Jewelry & Watches
- Lawn & Garden
- Lighting
- Militaria
- Motor Vehicles
- Music & Musical Instruments
- Silver & Silver Plate
- Sports Memorabilia, Trading Cards & Ephemera
- Toys & Video Gaming
- View All Auctions
- Auctions
- Estate Sales